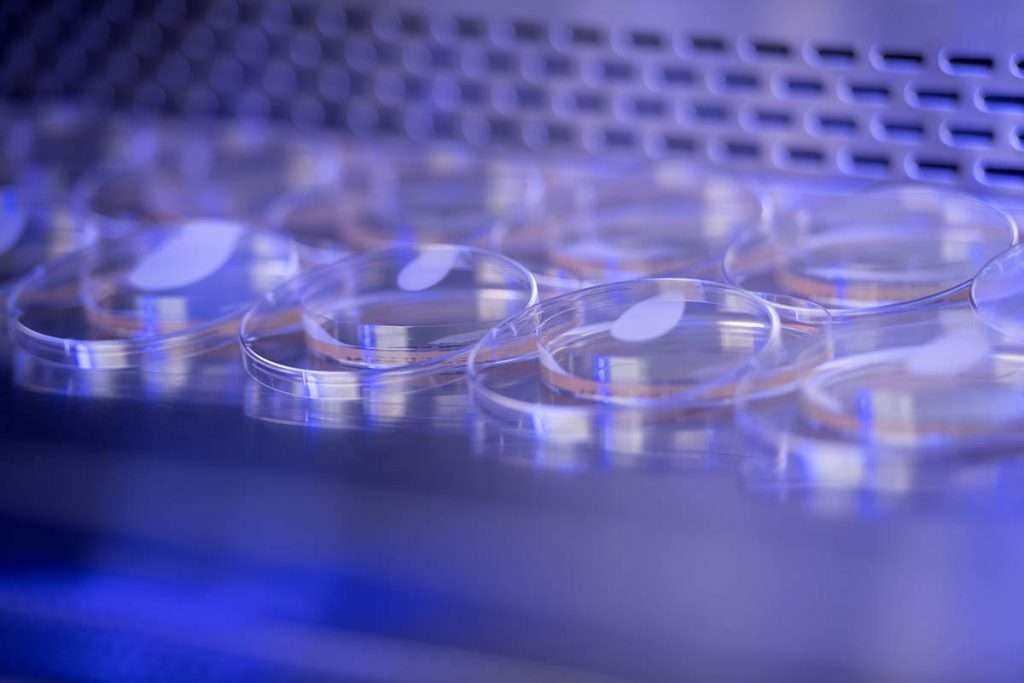
creative lab photography

Industry.
Guelph Industrial Photography
We know industry
Known as The Royal City, Guelph sits in the seat of Wellington County and is easily accessed from Kitchener, Hamilton, and much of the GTA. Its craft beer scene and independent eateries offer much to be savored, whereas its historic buildings, picturesque views, and landmark cultural facilities provide countless reasons to visit and play. With its community spirit and neighbourly vibe, the City of Guelph offers the best of both worlds: big city amenities and opportunity within a small town setting.
Recently, Guelph was deemed as having one of the fastest growing economies in Canada – in large part due to agri-food, life sciences, and advanced manufacturing, which accounts for 360 businesses and countless factories and industrial job sites worth capturing.

What we do
Industrial photography services in Guelph
Photography speaks when words fail. We can help communicate the story of your business.
“.

Manufacturing
Images of the facility, steps to produce a product.

Buildings
Photography of factories, yards, work sites etc.

Equipment
Machinery both large and small.

Finished Products
Final products, raw material etc.

Workers
Photography of staff, managers, trades and more.

Aerials
Drone images and video of sites, buildings etc.

Compliance
Pictures showing adherence to safety and standards.

Large Machinery
Equipment used in large scale production of products.
How we are different
Photography Services
For over a decade Robert Lowdon Photography has been supplying high quality industrial photography to clients all over Canada. As an experienced industrial photographer Robert knows how to effectively and safely work on any construction site. Our company believes that the success of our photography business completely relies on the success of our clients.
Since the start, we have never missed a deadline. The price we quote is the price we invoice. We deliver on time and on budget every single time. We are extremely professional, responsive, quick to offer help, and we completely guarantee all our work from start to finish. Simply put we will do what ever we can to help you out, and ultimately make your Brampton industrial photography project a success. No other photographer will work harder for your business.
Our Work
Just a small sample of some of the great industrial projects we have been happy to be a part of throughout Canada.

Why You Need Photography
Professional photography makes all aspects of your marketing perform the way it should. Images will make customers want to interact with your brand, as well as help them relate to your product. Most importantly, it will allow them to visualize using your product or service before making a purchasing decision. This applies just as much as a new home buyer buying a house, a customer planning on visiting a retail store or a large company choosing who the right firm is to develop their next great building project.
%
Increase Brand Awareness
%
Makes Marketing More Effective
%
Makes Website More Effective
%
Increase in New Clients
What is an Industrial Photographer Anyway?
An industrial photographer is a photographer that specializes or has training in photographing industrial operations. They have experience working on industrial work sites. A good industrial photographer is familiar with the proper safety processes and regulations.
When we talk about industrial photography, we are referencing the heavy manufacturing, chemical processing, transportation, construction sectors and more. We focus on business that makes, produces and transports materials and / or finished goods. Basically, the businesses that support our economy.
Hiring a Photographer for Your Industrial Operation Is Easy
Tell Us About Your Project
We'll Send Back a Quote
We'll Book a Date for the Shoot

Choose Robert Lowdon Photography for Your Next Project
As a professional photographer, Robert has years of experience working on different job sites around Canada. Our company believes in creating a collaborative experience for our clients. We use state of the art equipment, are professionally trained in photography, and licensed to carry out advanced drone operations.
We have industry standard safety training. We are comfortable working at heights, in adverse environments, and know how to work with proper care around heavy machinery.
We produce high quality images that help our clients win business. We pride ourselves on being easy to work with and getting the job done well.
We guarantee the quality of our work from start to finish.
PROVIDE A NEW PERSPECTIVE ON TECHNOLOGY, INNOVATION, AND THE
WORKFORCE OF YOUR INDUSTRY.
Hands down, you need amazing images to attract customers to your business. Customers want to see the incredible work you can do. To get those images, you need an expert photographer from Robert Lowdon Photography.
